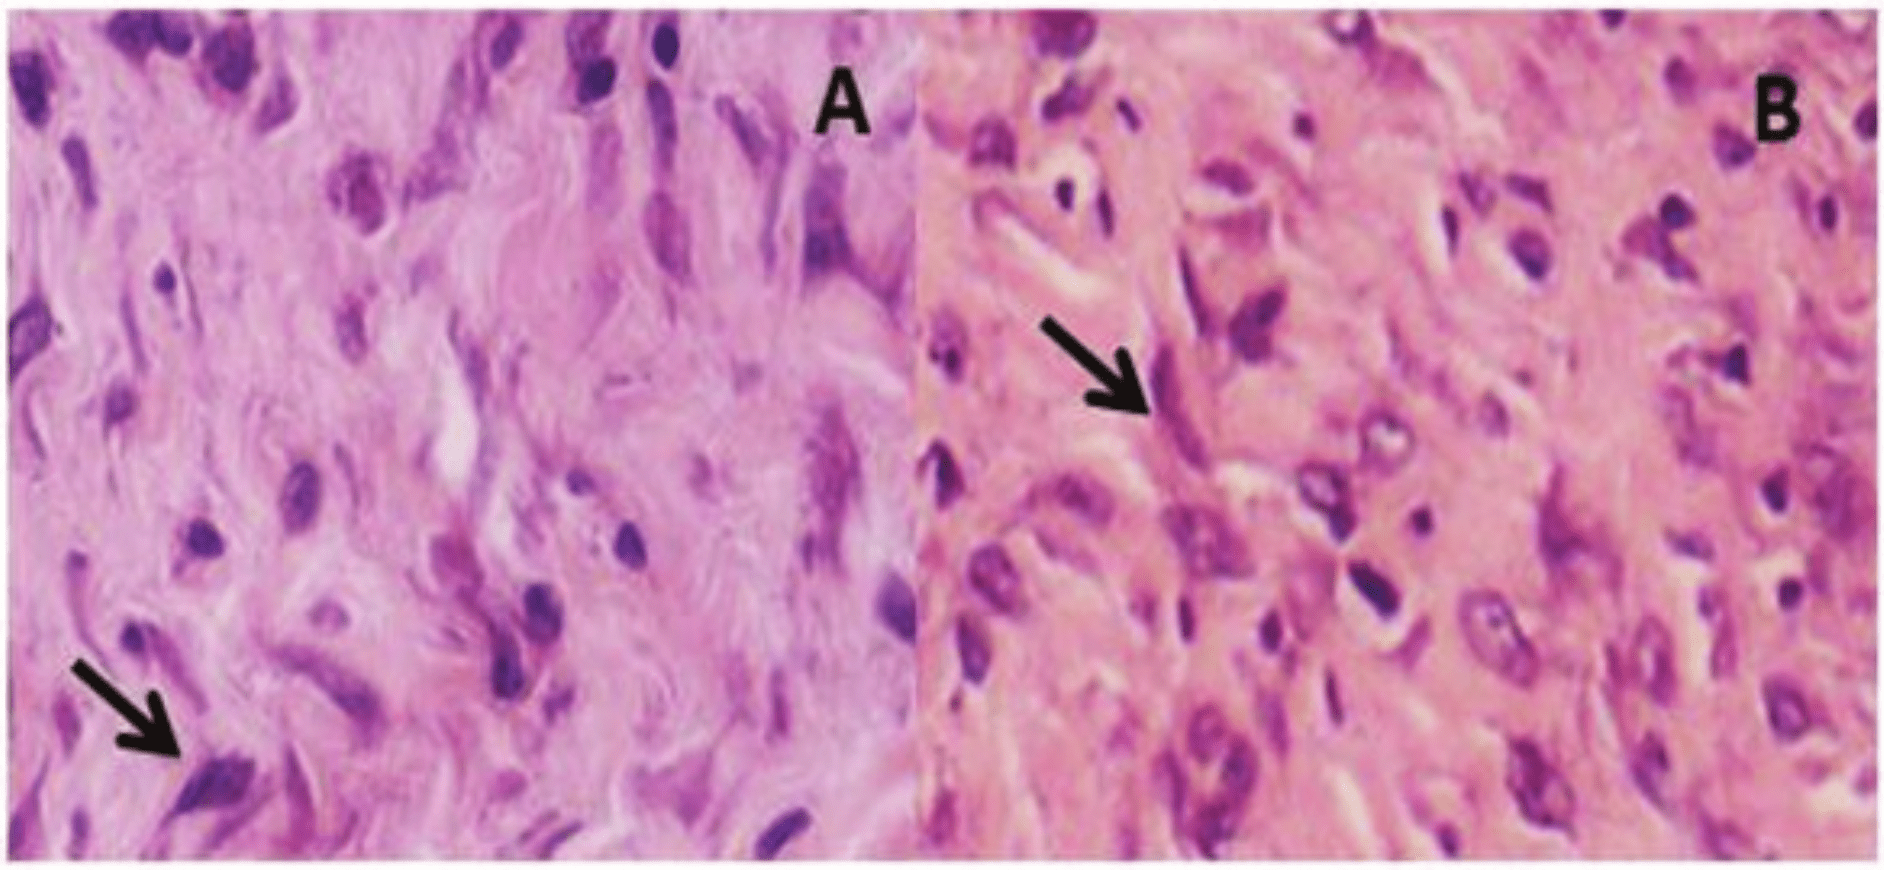
Histological section rat skin stained with HE (fibroblast is indicated by the
arrow) obtained from control rats (A) and the group treated with pure protein
extract (B). Increase of 40 X

Biotecnologia
In vitro enzyme activity and in vivo healing activity of the protein extract from pineapple peel
In vitro enzyme activity and in vivo healing activity of the protein extract from pineapple peel
Acta Scientiarum. Biological Sciences, vol. 41, 2019
Universidade Estadual de Maringá

This work is licensed under Creative Commons Attribution 4.0 International.
Received: 25 January 2018
Accepted: 17 September 2018
Abstract: The pineapple is a fruit that has wide acceptance worldwide both in natural form, as industrialized. Your peel is a residue generated by food industries and from this residue can obtain a protein extract which is a good source of bromelain. This study aimed to obtain a protein extract from pineapple peel, evaluate its enzyme activity and its healing properties in skin lesions in rats. Seven animal groups were used: control, treated with 5% of protein extract, 10% of protein extract and pure protein extract; 5% of commercial bromelain, 10% of commercial bromelain and pure commercial bromelain. The animals were subjected to a tissue incision and treated for 21 days. Proteolytic and specific activities of the protein extract were 1.30 U mg-1 and 45 x 10-3 U µg-1 and, for commercial bromelain, 1.04 U mg-1 and 6 x 10-3 U µg-1, respectively. In the histology of the lesion, there was no significant difference between the control and treated groups; however, macroscopically, the prepared topical formulations assisted in the recovery of skin lesions, providing a significant reduction in their width, in the groups treated with pure protein extract, 5 and 10% commercial bromelain, and pure bromelain.
Keywords: bromelain, skin lesion, enzyme activity, pineapple and healing.
Introduction
Pineapple (Ananas comosus) is a tropical fruit of the Bromeliaceae family, which has great economic importance, and Brazil is one of the world's leading producers (Viana, Reis, Jesus, Junghans, & Souza, 2013; Ramallo & Mascheroni, 2012). The edible part of the plant is the pulp, a portion which only represents 23% of the total, while the remainder, consisting of stem, leaf, peel, crown and stalk, are considered an agricultural waste and are not fully exploited, resulting in economic losses (Araújo, Sabaa-Srur, Rodrigues, Manhães, & Canto, 2009; Nor, Ramchandran, Duke, & Vasiljevic, 2015).
Bromelain is a mixture of different thiol endopeptidases and other components like phosphatases, glucosidase, peroxidases, cellulases, glycoproteins, carbohydrates, and several protease inhibitors (Pavan, Jain, Shradalha, & Kumar, 2012; Kennedy & Turan, 1999). In Brazil, bromelain is not produced for commercial purposes. However, this enzyme can be obtained from all parts of the pineapple, including waste from the food industry. Therefore, the reuse of this waste for bromelain extraction is an alternative capable of adding commercial value to these by-products, favoring new markets.
Several studies have attributed numerous therapeutic properties to bromelain, such as: anti-inflammatory action, inhibition of platelet aggregation, fibrinolytic activity, antitumor action, modulation of cytokines and immunity, debridement properties of the skin, increased absorption of other drugs, mucolytic properties, digestion facilitation, healing acceleration and improved circulation and cardiovascular system (Orsini, 2006, Bromelain, 2010; Bala et al., 2012; Si-Yu et al., 2012; Rosenberg et al., 2014). It is a mixture of cysteine proteinases, which has been widely used in burn debridement (Rosenberg et al., 2004; Singer et al., 2010). Wound healing is perfectly coordinated cascade of cellular, molecular and biochemical events occurring that interact to tissue reconstitution (Campos, Branco, & Groth, 2007). Healing is a process that occurs to restore the anatomical and functional integrity of tissues and is of great interest to health professionals, since its efficiency accelerates the patient's rehabilitation process (Leite, Oliveira, Soares, & Barrocas, 2012; Beheregara et al., 2014).
Among the products of dermatological interest, noteworthy are the action topical products incorporated in pharmaceutical forms, these can in turn allow reestablishment of integrity of the skin after possible aggressions. In this context, bromelain has potential application for the treatment of skin wounds, accelerating the healing process. Given the above, this study aimed to extract bromelain from pineapple peel, obtaining a protein extract, compare its enzymatic activity with that of commercial bromelain and evaluate its healing properties in skin lesions in rats.
Material and methods
Raw material
Pineapples (Ananas comosus L. Merril) cultivar Pérola, 30 units, from the State of Pará, were obtained at Central de Abastecimento de Minas Gerais (CEASA), in the city of Contagem, metropolitan region of Belo Horizonte. Bromelain commercial (Sigma-Aldrich) was purchased from international laboratory and used as a standard.
Preparation of pineapple peel crude extract
The fruits were washed and sanitized with 200 mg L-1 sodium hypochlorite for 10 minutes. Pineapples were rinsed with distilled water and subsequently dried at room temperature, weighed, had their crowns removed and were then peeled with the help of a knife. The peel was processed in a Walita food processor, filtered at room temperature and centrifuged at 6000 x g for 15 minutes at 4°C. The precipitate was discarded and an activator solution containing 4 x 103 mol-1 EDTA and 10-2 mol-1 cysteine was added to 2760 mL of the supernatant, for the obtention of a 0.5% w/v final activator solution, according to Silvestre et al. (2012), with modifications. This solution was called crude extract, which was frozen in a freezer.
Preparation of proteic extract
The crude extract was precipitated for each 100 mL crude extract, 200 mL of 80% ethyl alcohol was added at 5°C under constant stirring, in an ice bath. The extract was then centrifuged at 2912 x g for 20 minutes at 5°C, the supernatant was removed and the precipitate was frozen, lyophilized, milled and stored under refrigeration until the analyses were performed.
Determination of protein content
The total protein content was determined by the Coomassie blue technique, according to Bradford (1976), using bovine serum albumin (BSA) as a reference protein. Color intensity was measured at 595 nm.
Determination of the proteolytic activity of the protein extract from pineapple peel and commercial bromelain
The determination of proteolytic activity was performed according to Kumar (2002) and Tremacoldi and Carmona (2005). Albumin was used as the substrate to be hydrolyzed by bromelain. The albumin solution and the protein extract were prepared with McIlvaine buffer solution (0.2 mol-1 sodium phosphate and 0.1 mol-1 citric acid) at pH 5.0, and incubated in a water bath at 37°C for 30 minutes. After incubation, the reaction was quenched with 1.5 mL trichloroacetic acid at 10%, the mixture was centrifuged at 15,000 x g at 4°C and the absorbance was measured at 280 nm in a UV-VIS spectrophotometer.
A tyrosine standard curve was constructed with an L-tyrosine (Sigma) solution (100 µg mL-1), diluted in 0.1 mol-1 HCl. The enzyme activity was expressed as U mg-1, corresponding to µg (tyrosine released) min-1 mL-1.
Standardization of optimal conditions for the enzymatic assay
The optimal conditions of the enzymatic assay were tested in the protein extract and in commercial bromelain; pH, temperature, enzyme concentration and substrate concentration were evaluated, as described by Kumar (2002) and Tremacoldi and Carmona (2005).
Determination of the specific activity of the protein extract from pineapple peel and commercial bromelain
The specific activity was calculated from the ratio between total proteolytic activity and total concentration of sample proteins, according to the Figure (1) and was expressed in U µg-1.

Figure 1
Equation specific activity
Cream preparation
Commercial bromelain and pineapple peel proteic extract were incorporated in nonionic Polawax, according to Formulário Nacional - Farmacopéia Brasileira (Brasil, 2012), at concentrations of 5 and 10%; pH values in the cream were measured by indicator strips.
Biological assay
The biological assay was approved by the Ethics Committee on Animal Use (CEUA) of Universidade Federal de Lavras - UFLA, under protocol N0 007/2012.
Thirty five young adult female Wistar rats (Rattus norvegicus) from the vivarium of the Department of Veterinary Medicine (UFLA) were used, with an initial weight of 185 ± 10 g. The animals were randomly divided into seven groups (n = 5/each). Group C- control there was no treatment, group 5% EP -treated with cream containing 5% protein extract, group 10% EP-treated with cream containing 10% protein extract, group EP-treated with pure powder protein extract, group 5% B-treated with cream containing 5% commercial bromelain , group 10% B- treated with cream containing 10% commercial bromelain and group B-treated with commercial pure powder bromelain (B).
The animals were kept in individual cages in a room with temperature of 25 ± 3ºC (12 hours light/dark cycle), where they received rodent chow and water ad libitum for one week for adaptation; subsequently, the experiment started.
Induction of skin lesions
The animals were weighed and anesthetized with 35 mg kg-1 thiopental, intraperitoneally, and 2% lidocaine, a local anesthetic, infiltrated in the area where the incision was made. After trichotomy of part of the dorsal region of the animals, the area to be damaged was marked; therefore, a ruler with circular area and 1cm diameter was used. A skin opening was then made in the dorsal region of the animals, with the aid of surgical scissors. In this study, the width and length of the lesion were evaluated, in order to assess tissue contraction that occurs in healing.
Treatment
For 21 days, the animals of the treated groups received daily treatment with: cream with 5% protein extract (5% EP); cream with 10% protein extract (10% EP); pure protein extract (EP); cream with 5% commercial bromelain (5% B); cream with 10% commercial bromelain (10% B) and pure commercial bromelain (B). Disposable wooden spatulas were used for the application of cream formulations, and powder samples (EP and B) were sprinkled onto the lesions. The control group received no treatment. The length and width of the lesions were measured weekly with the aid of a caliper by the linear measurement of the vertical and horizontal axes of the lesion.
At the end of the experiment, euthanasia was performed using thiopental, until the absence of vital signs was observed.
Histological analysis
After euthanasia, the skin lesions were fixed in 10% formol, sectioned, dehydrated and diaphanized at room temperature. They were then embedded in paraffin, subjected to trichotomy and stained with hematoxylin-eosin.
Statistical analysis
Enzyme assays were performed in triplicate and the results were expressed as mean ± standard deviation. The results for the size of the lesion were subjected to analysis of variance and Scott-Knott test at 5% probability, using the program Ferreira (2003).
Results and discussion
Standardization of optimal conditions for the enzymatic assay
It was standardized ideal conditions for enzymatic assay, as depending on the enzyme source, harvest time may change its optimal conditions of action. Enzyme activity was evaluated at different pH conditions (3, 4, 5, 6, 7, 8 and 9), temperatures (30, 40, 50, 60, 70 and 80ºC), enzyme concentrations (1, 2, 4, 6, 8 and 10 mg mL-1) and substrate concentrations (0.10, 0.30, 0.50, 0.70, 0.90 and 1%).
The selected enzyme concentration was 4 mg mL-1 and the substrate concentration was 0.5%, concentrations that are highlighted both for commercial bromelain and the protein extract.
The best activity of bromelain was at pH 6.0 for both the protein extract as for commercial bromelain. França-Santos, Alves, Leite, and Fernandes (2009), testing extracted bromelain from pineapple fruit presented optimum pH of 5.0, as Silvestre et al. (2012) found for the protein extract of pineapple an optimum pH of 7.0. This difference can be attributed to purification methodology and the part of the plant that was used (stem, fruit, peel or pulp) may influence the action of the enzyme.
Regarding temperature, the maximum activities of commercial bromelain and protein extract were different. For the protein extract, the optimum temperature observed was 50°C while, for commercial bromelain, this temperature was 70°C. This difference can be attributed to the fact that purified enzymes were more resistant to high temperatures than non-purified ones, and it may also be related to the origin of bromelain, since enzymes extracted from different parts of the plant (stem, fruit, peel or pulp) may have different behaviors. Therefore, the temperature of 50°C was selected since, above this temperature, the enzyme may be denatured in the protein extract.
The review by Bala et al. (2012) relates to the characterization of many authors, who found the optimum temperature for stem bromelain from 50 to 60°C while the fruit bromelain the optimum temperature 37-70°C.
The ideal conditions for the enzyme assay were standardized, since the optimal conditions for the action of bromelain may change, depending on enzyme source and fruit harvest time.
Protein content, proteolytic and specific activity of the protein extract from pineapple peel and commercial bromelain
The results of protein content, proteolytic activity and specific activity of the protein extract and commercial bromelain are shown in Table 1.

Table 1.
Protein, proteolytic activity and specific activity of commercial bromelain and the protein extract from pineapple peel
The enzymatic activity of bromelain can be expressed in proteolytic activity or even in specific activity, and in this, taken into consideration the amount of proteins presents in the extract.
The protein extract of pineapple peel had lower protein content than that found in commercial bromelain, a result which was anticipated, since commercial bromelain is a purified protein. However, the proteolytic activity of the protein extract (1.30 U mg-1) was higher than that found in commercial bromelain (1.04 U mg-1), indicating that a simple extraction methodology can be used to extract the enzyme.
The specific activity of bromelain in the protein extract of the peel was higher than commercial bromelain (45 x 10-3 U µg-1 and 6 x 10-3 U µg-1, respectively); thus, the protein extract can be considered a good bromelain source with high specificity. In studies with pineapple peels, Silvestre et al. (2012) found a content of 1.6 U mg-1 in pH 6.0 for specific activity, this is probably due to the difference between the sample and the methodology used.
The variations observed in the specific activity of bromelain are probably due to the difference in growing conditions, soil and climate, sample type and different extraction methodologies.
Chemical characteristic of the cream
Cream formulations were prepared using Polawax, pH 5.5. Cream EP 5 and 10% showed small granulations and bromelain with 5 and 10% commercial cream was quite homogeneous. The incorporation of 5% bromelain, both by the protein extract, and the commercial bromelain, caused a decrease in the pH of the wax to 5.0, while the addition of 10% bromelain, by the protein extract or commercial bromelain, resulted in a wax with pH 4.5. The reduction in pH by the addition of bromelain was expected, since it is an acidic protein and skin pH is slightly acidic (4.6-5.8), which contributes to bactericidal and fungicidal protection on its surface (Leonardi, Gaspar, & Campos, 2002); the cream will not influence skin pH and this natural protection.
Biological assay
The development in wound healing during the experiment is shown in Figures 2A and 2B. It is observed that, throughout the days, there was a reduction in lesion size. However, this reduction was more evident in width (Figure 2B) than in the length of the wound (Figure 2A), a behavior found in all groups. The reduction in lesion length is due to contraction and epithelialization mechanisms that occur during the healing process (Townsend, Beauchamp, Evers, & Kenneth, 2015).

Figure 2
A) Skin lesion in animals of the control group, on the 1st, 7 and 14th days after surgery, respectively and B) Skin lesion on the 21st day in control and treated groups (EP), respectively.
In the evolution of healing of skin wounds, there was the formation of surface crusts up to the seventh day, both in the control group and in the treated groups. However, the appearance of crusts in the treated groups occurred within the first 3 days after surgery, while the presence of crust was observed from the fourth day in the control group. Eurides et al. (1998) and Monteiro, Correa, Pavanelli, Valentini and Biazon (2015) reported that the presence of crust on the wound favors the healing process; therefore, the treatment with bromelain cooperated with wound healing. Over the days, there was a thickening of the crust in all groups. However, from the 14th day, the crust stood out, evolving into granulation and epithelialization tissue until the 21st day.
In Figure 3A, it is noted that, over the weeks, there was a reduction in lesion length for all groups analyzed. At Week 0, the lesion was measured on the day of surgery, and it was possible to observe 100% lesion length. Over the weeks, there was no significant difference in lesion length of the control and treated groups. This is probably due to the fact that tissue shrinkage occurred in the horizontal direction and caused a slight reduction in length, forming a scar which appears as a vertical line, and can be seen in Figure 2B.
In week 0, 100% lesion width were observed (Figure 3B) and, over the weeks, there was a reduction in the width of these lesions for all groups analyzed.

Figure 3.
A) Percentage of length of skin lesions in rats from the control group and those treated with protein extract and bromelain, during the weeks. B) Percentage of width of skin lesions in rats from the control group and those treated with protein extract and bromelain, during the weeks. Means followed by the same lowercase letters between treatments and uppercase between weeks, do not differ by the Scott-Knott test at 5%.
In Figure 2A, over the weeks, there was no significant difference in lesion length of the control and treated groups. This is probably due to the fact that tissue shrinkage occurred in the horizontal direction and caused a slight reduction in length, forming a scar which appears as a vertical line, and can be observed in Figure 3B.
Width reduction in groups EP, 5% B, 10% B and B was significantly higher than that shown by groups 5% EP, 10% EP and control. Groups treated with the formulations 5% EP and 10% EP were not different from the control at the end of the experiment. This is probably the cream absorption protein extract was lower due to its more granulation, making it less had healing activity despite having larger specific and proteolytic activities that commercial bromelain.
However, although not purified, the protein extract showed a similar result to commercial bromelain, when applied directly to the lesions, indicating that bromelain has the potential to aid in wound healing, even when extracted from pineapple peel.
Bromelain has properties such as: debriding; anti-inflammatory, accelerator of granulation tissue formation, and wound healing processes (Candido, 2001; Maurer, 2001; Jorge & Dantas 2003). Thus, the results observed in this study indicate that the healing potential of the formulations prepared may be attributed to the healing properties of bromelain. Si-Yu et al (2012) observed improvement in wound healing using topical bromelain in pigs, due to enzimatic debridement improve the perfusion and oxygenation of the wound site is critical to ensure appropriate healing because it involves the supply oxygen and nutrition, elimination of metabolic waste, control of infection, and cytokine release in the wound.
Hu et al. (2011) also demonstrated the effect of bromelain in wound debridement caused by firearms in pigs. They realized that a bromelain solution (10 mg mL-1) rapidly hydrolyzed the wounded tissue with minimal effect on normal tissue, showing advantages in the enzymatic debridement associated with a single incision wound, in place of conventional surgical debridement widely used to debride firearm injuries.
According Orsini (2006) bromelain may be also of interest for plastic surgery because of its ability to reduce pain, swelling, inflammation and platelet aggregation, and enhance antibiotic effect, all beneficial for postoperative recovery. Aichele, Bubel, Deubel, Pohlemann, and Oberringer (2013) studied the effect of bromelain on tissue regeneration at the cellular level through in vitro wound healing assay. They used two major healing models of soft tissue, fibroblasts and microvascular endothelial cells. The results showed that the therapeutic use of bromelain in the treatment of chronic wounds is very promising.
According to this study bromelain shows a potential recovery of skin lesions, further study must be carried due the small sample size.
Histological analysis
Histological analysis at week 3 (Figure 4) showed that, at this stage, epithelialization of lesions occurred, and the discreet presence of fibroblasts was observed in 20% of the blades for all groups, with no difference in optical microscopy at the end of the experiment. Along weeks, the lesions were not assessed microscopically, due to the amount of available animals. Therefore, it is important to expand the experimental study, using more animals.
Figure 4
Histological section rat skin stained with HE (fibroblast is indicated by the arrow) obtained from control rats (A) and the group treated with pure protein extract (B). Increase of 40 X
Conclusion
Enzyme activities of the protein extract indicate that pineapple peel is a good source of bromelain. The analysis of the healing process, from a macroscopic point of view, shows that the protein extract obtained from pineapple peel plays an important role in the recovery from acute cutaneous lesions in rats, resulting in a reduction in the width of the lesion and accelerating the healing process, which reinforces its therapeutic potential.
Acknowledgements
The authors would like to thank CNPq, CAPES and FAPEMIG for the financial support.
References
Aichele, K., Bubel, M., Deubel, G., Pohlemann, T., & Oberringer, M. (2013). Bromelain down-regulates myofibroblast differentiation in an in vitro wound healing assay. Naunyn Schmiedebergs Archives of Pharmacology, 386(10), 853-863. doi: 10.1007/s00210-013-0890-z
Araújo, K. G., Sabaa-Srur, A. U., Rodrigues, F. S., Manhães, L. R., & Canto M. W. (2009). Utilização de abacaxi (Ananas comosus L.) cv. Pérola e Smooth cayenne para a produção de vinhos - estudo da composição química e aceitabilidade. Ciência e Tecnologia em Alimentos, 29(1), 56-61. doi: 10.1590/ S0101-20612009000100009.
Bala, M., Ismail, N. A., Mel, M., Saedi, M., Salleh, H. M., Salleh, A., … Jami, M. S. (2012). Bromelain production: current trends and perspective. Archives des Sciences, 65(11), 369-399.
Beheregara, W. K., Gianotti, G. C., Leal, J. S., Garcez, T., & Contesini, E. A. (2014). Eletroestimulação na cicatrização de feridas cutâneas experimentais em coelhos. Ciência Rural, 44(5), 878-883. doi: 10.1590/S0103-84782014000500019.
Bradford, M. M. (1976). A rapid and sensitive method for the quantitation of microgram quantities of protein utilizing the principle of protein-dye binding. Analytical Biochemistry, 72(1-2), 248-254.
Brasil. Ministério da Saúde. Agência Nacional de Vigilância Sanitária. (2012). Formulário. Retrieved from Podemos colocar o link http://portal.anvisa.gov.br/documents/33832/259372/FNFB+2_Revisao_2_COFAR_setembro_2012_atual.pdf/20eb2969-57a9-46e2-8c3b-6d79dccf0741
Bromelain, Monograph. (2010). Alternative Medicine Review, 15(4), 361-368. PMID: 21194252
Campos, A. C. L., Branco, A. B., & Groth, A. K (2007). Cicatrização de feridas. Arquivos Brasileiros de Cirurgia Digestiva, 20(1), 51-58. doi: 10.1590/S0102-67202007000100010
Candido, L. C. (2001) Nova abordagem no tratamento de feridas. São Paulo, SP: Senac.
Eurides, D., Mazzanti, A., Gonçalves, G. F., Belleti, M. E., Silva, L. A. F., Fioravanti, M. C. S, ... Ogata, A. S. (1998). Aspectos morfológicos, morfométricos e histológicos da reparação tecidual de feridas cutâneas de camundongos tratadas com óleo de copaíba (Copaifera langsdorfii), Veterinária Notícias, 4(3), 77-82.
Ferreira, D. F. (2003). SISVAR - Sistema de análise de variância para dados balanceados: programa de análises estatísticas e planejamento de experimentos. Versão 4.6. (Software). Lavras, MG: UFLA.
França-Santos, A., Alves, R. S., Leite, N. S., & Fernandes, R. P. M. (2009). Estudos bioquímicos da enzima bromelina do Ananas comosus (abacaxi). Scientia Plena, 5(11), 101-111.
Jorge, A. S., & Dantas, S. R. P. (2003). Abordagem multiprofissional do tratamento de feridas. São Paulo, SP: Atheneu.
Hu, W., Wang, A. M., Wu, S. Y., Zhang, B., Liu, S., Gou, Y. B., & Wang, J. M. (2011). Debriding effect of bromelain on firearm wounds in pigs. The Journal of Trauma: Injury, Infection, and Critical Care, 71(4), 966-972. doi: 10.1097/TA.0b013e3182028929.
Kennedy, J., & Turan, N. (1999). Handbook of proteolytic enzymes, Alan J. Barrett, Neil D. Rawlings & J. Fred Woessner (Eds.), Academic Press, 1998, pp. xxx + 1666, ISBN: 0-12-079370-9 [BookReview]. Bioseparation, 8(6), 340-341. doi: 10.1023/A:1008196809828
Kumar, C. G. (2002). Purification and characterization of a thermostable alkaline protease from alkalophilic Bacillus pumilus. Letters in Applied Microbiology, 34(1), 13-17. PMID: 11849485
Leite, A. P., Oliveira, B. G. R., Soares, M. F., & Barrocas, D. L. R. (2012). Uso e efetividade da papaína no processo de cicatrização de feridas: uma revisão sistemática. Revista Gaúcha de Enfermagem, 33(3), 198-207. doi: 10.1590/S1983-14472012000300026
Leonardi, G. R., Gaspar, L. R., & Campos, P. M. B. G. (2002). Estudo da variação do pH da pele humana exposta à formulação cosmética acrescida ou não das vitaminas A, E ou de ceramida, por metodologia não invasiva. Anais Brasileiros de Dermatologia, 77(5), 563-569. doi: 10.1590/S0365-05962002000500006
Maurer, H. R. (2001). Bromelain: biochemistry, pharmacology and medical use. Cellular and Molecular Life Science, 58(9), 1234-1245. doi: 10.1007/PL00000936
Monteiro, E. A., Correa, J., Pavanelli, M. F., Valentini, S. A., & Biazon, A. C. B. (2015). Avaliação do extrato hidroetanólico das folhas de Moringa oleifera no processo de cicatrização em lesões cutâneas de ratos. SaBios: Revista de Saúde e Biologia, 10(3), 25-34.
Nor, M. Z. M., Ramchandran, L, Duke, M., & Vasiljevic, T. (2015). Characteristic properties of crude pineapple waste extract for bromelain purification by membrane processing. Journal of Food Science and Technology, 52(11), 7103-7112. doi: 10.1007/s13197-015-1812-5
Orsini, R. A. (2006). Bromelain. Plastic and Reconstructive Surgery, 118(7), 1640-1644. doi: 10.1097/01.prs.0000 242503.50548.ee
Pavan. R., Jain, S., Shradalha, & Kumar, A. (2012). Properties and therapeutic application of bromelain: a review. Biotechnology Research International, 2012(Article ID 976203), 1-6. doi: 10.1155/2012/976203
Ramallo, L. A., & Mascheroni, R. H. (2012). Quality evaluation of pineapple fruit during drying process. Food and Bioproducts Processing, 90(2), 275-283. doi: 10.1016/j.fbp.2011.06.001
Rosenberg, L., Krieger, Y., Bogdanov-Berezovski, A., Silberstein, E., Shoham, Y., Adam, J., & Singer, A. J. (2014). A novel rapid and selective enzymatic debridement agent for burn wound management: A multi-center RCT. Burns, 40(3), 466-477. doi: 10.1016/ j.burns.2013.08.013.
Rosenberg, L., Lapid, O., Bogdanov-Berezovsky, A., Glesinger, R., Krieger, Y., Silberstein, E,… Singer, A. J. (2004). Safety and efficacy of a proteolytic enzyme for enzymatic burn debridement: A preliminary report. Burns, 30(8), 843-850. doi: 10.1016/j.burns.2004.04.010
Silvestre, M. P. C, Carreira, R. L., Silva, M. R., Corgosinho, F. C., Monteiro, M. R., & Morais, H. A. (2012). Effect of pH and temperature on the activity of enzymatic extracts from pineapple Peel. Food and Bioprocess Technology, 5(5), 1824-1831. doi: 10.1007/s11947-011-0616-5
Singer, A. J., Mc Clain, S. A., Taira, B. R., Rooney, J., Steinhauff, N., & Rosenberg, L. (2010). Rapid and selective enzymatic debridement of porcine comb burns with bromelain derived Debrase: acute-phase preservation of noninjured tissue and zone of stasis. Journal of Burn Care Research, 31(2), 304-309. doi: 10.1097/BCR.0b013e3181d0f4d4.
Si-Yu, W., Hu, W., Zhang, B. O., Shuai, L., Wang, J. M., & Wang, A. M. (2012). Bromelain ameliorates the wound microenvironment and improves the healing of firearm wounds. Journal of Surgical Research, 176(2), 503-509. doi: 10.1016/j.jss.2011.11.1027.
Tremacoldi, C. R., & Carmona, E. C. (2005). Production of extracellular alkaline proteases by Aspergillus clavatus. World Journal of Microbiology and Biotechnology, 21(2), 169-172. doi: 10.1007/s11274-004-2724-0
Townsend, C. S., Beauchamp, D., Evers, M., & Kenneth, M. (2015). Sabiston: Tratado de cirurgia. Rio de Janeiro, RJ: Elsevier.
Viana, E. S., Reis, R. C., Jesus, J. L., Junghans, D. T., & Souza, F. V. D. (2013). Caracterização físico-química de novos híbridos de abacaxi resistentes à fusariose. Ciência Rural, 43(7), 1155-1161. doi:10.1590/S0103-84782013005000075.